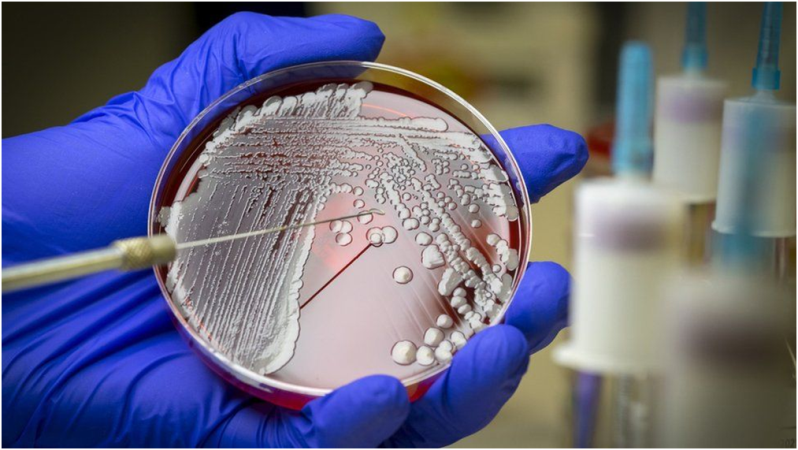

У одній з минулих статей ми говорили: «Уявіть, на що будуть здатні ШІ, спеціально створені для наукових досліджень». І ось з’явилась відповідь: на що.
- Створення антибіотика проти супербактерії
До списку критично небезпечних біологічних загроз входить бактерія, про яку ви, напевно, не чули. Acinetobacter baumanni (AB) — бактерія, яка може викликати смертельно небезпечний менінгіт, пневмонію, зараження ран і крові, а також урологічні інфекції. Вона маленька і непомітна, і її натуральне середовище проживання досі невідоме. Вона користується будь-якою слабкістю імунітету, щоб пролізти у вразливу частину організму і почати розмножуватись. Вона надзвичайно стійка до антибіотиків. Саме бактерія Баумана відповідальна за багато внутрішніх інфекцій у лікарнях.
До нещодавнього часу спосіб боротися з нею не був визначений... Аж доки до цього не застосували штучний інтелект.
Епідеміологія у наш час схожа на перегони озброєнь. Ліки сильнішають, проте сильнішають і хвороби. Мікроби розмножуються надзвичайно швидко, і навіть якщо антибіотик вбиває 99.9%, залишається кілька таких бактерій, що завдяки мутаціям пережили його дію. Їм допомагають ті люди, хто не допиває курси антибіотиків до кінця і таким чином дає бактеріям, що вижили, шанс виробити стійкість. Постійно з’являються нові штами, невразливі до все більшої кількості антибіотиків.
Одна із таких — Acinetobacter baumanni. І використання ШІ у науці дає можливість розв'язувати подібні проблеми.

Дослідники з Канади та США використали спеціально побудований ШІ, щоб оцінити ефективність 6680 хімічних речовин, ефективність яких не була визначена. Після години роботи ШІ надав лист з 240 найбільш ефективних у боротьбі з бактерією. Ці 240 були протестовані у лабораторії, і дев’ять із них підходили для боротьби, а один — абауцин — виявився надзвичайно ефективним. Він зміг вилікувати зараження ран у лабораторної миші та вбити бактерію Баумана на зразках з пацієнтів.
Таким чином вчені зекономили дуже багато часу, який був би затрачений на віртуальні й реальні тестування всіх майже семи тисяч речовин.
Це майже ідеальний приклад того, як треба застосовувати ШІ у науці.

- Допомога Великому Адронному Колайдеру у Швейцарії
Штучний інтелект дуже гарно працює з великими обсягами інформації, які людина нездатна обробити. Тож, коли вчені підступають до надзвичайно складних чи великих питань, електронні мізки стають їм у пригоді.
Так на Великому Адронному Колайдері (ВАК) у Швейцарії ШІ використовують з 2019 року, щоб оцінювати події, що на надзвичайних швидкостях трапляються всередині машини. Наприклад, для того, щоб підвищити енергію зіткнень і навчити ВАК працювати на найвищих енергіях, довелося провести дванадцять тисяч тестів. З оціненням такої кількості настільки складних процесів не впоралося б ніяке програмне забезпечення, окрім ШІ. Зараз завдяки йому вчені підступають до того, щоб вирішити загадку темної матерії.

На малюнку — моделювання отримання бозона Хіггса в адронному колайдері.
- Майбутнє становище лісів в Америці
Та не тільки фізикам і хімікам він допомагає охоплювати неохопне. ШІ здатен оцінювати стан ґрунту, його вологість і родючість, стан води на великих просторах і складні, пов’язані багатьма факторами кліматичні системи. Так дослідник з Університету Флориди завдяки ШІ слідкує за станом лісів по всій Америці, при чому кожне дерево програма запам’ятовує і розглядає окремо, щоб потім створювати прогнози майбутнього становища лісів.

ШІ може допомагати систематизувати й оцінювати, прискорювати дослідження певних тем, а також слідкувати за комплексними процесами, які людина не може втримати у голові.
Таким чином штучний інтелект вже став в пригоді вченим: як тим, кому він допомагає за всім доглядати, так і тим, кого звільняє від одноманітної роботи й дає більше часу для досліджень і відкриттів.
Іван Синенко
